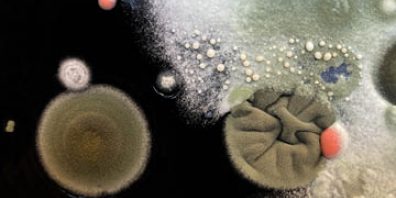

Es interesante observar como el concepto One Health ha traspasado fronteras y ha conseguido llevar herramientas y estudios del laboratorio a salas de arte, teatros, … Esto se debe a que la población general toma consciencia de la necesidad de disponer de una comunidad científica activa y cercana.
En este caso, una placa de cultivo, microbios y tiempo son los elementos básicos para un espectáculo científico llevado al teatro.
https://lnkd.in/gBP8UwcR